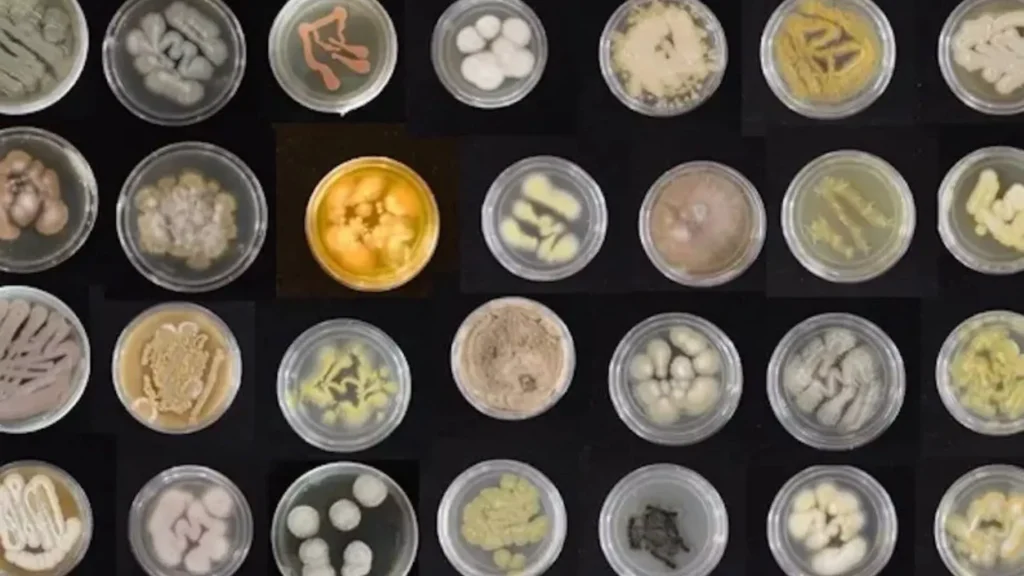

Hawaiili araştırmacılar, en yaygın plastiklerden biri olan poliüretanı hızla yemeleri için güçlü deniz mantarlarını eğitiyor.
Plastiğe bağımlı bir dünyada, plastiklerin bozulma süresi büyük bir sorun. Hawaii Üniversitesi bilim insanları deniz mantarlarına odaklanarak, bu soruna olası bir çözüm bulmak için yola çıktı.
Okyanuslardaki en büyük kirlilik kaynağı olan plastikler, bu ortamda hızla yayılan en büyük yaşam alanlarını oluşturuyor.
O’ahu adası çevresinde poliüretan plastikleri yiyen bir mantar türü keşfeden bilim insanları, bu mantarların plastiği doğadan uzaklaştırmak için yenilikçi bir yöntem olup olamayacağını araştırıyor. İlk bulgular umut vaat ediyor!
Ancak plastik uzmanları, biyolojik olarak parçalanabilen plastik çözümlerinin, plastik kirliliği kriziyle mücadele yöntemi olduğunu ancak tek başına yeterli olmayacağını savunuyor. Diğer bir yaklaşım ise, plastik üretimini baştan azaltmak.
Plastik kirliliğiyle mücadele etmek için halihazırda birçok mikroorganizma test ediliyor.
Plastiklere olan küresel bağımlılığımız ucuz, dayanıklı ve kullanışlı yapıları nedeniyle artmış olsa da, plastikler aslında hiçbir zaman tam anlamıyla çürümüyor. Bunun yerine, güneş ışığına, ısıya ve fiziksel güce maruz kaldığında mikroplastiklere dönüşüyor.
Mānoa’daki Hawaii Üniversitesi’nden (UH) araştırmacılar, deniz mantarlarının hem karadaki hem de sulardaki plastik atıkların temizlenmesi için “umut verici ve büyük ölçüde kullanılmamış” bir çözüm olduğuna inanıyor.
2009 yılına ait bir araştırmaya göre, her gün okyanusa sekiz milyon parça plastik atık karışıyor. Bu durum, okyanuslarımızda korkunç birikintilere yol açıyor; bunlardan biri, Hawaii’ye oldukça yakın olan Büyük Pasifik Çöp Yaması. Bu devasa deniz atığı yığını, Fransa’nın üç katı büyüklüğünde.
Bu plastiklerin birçoğu, deniz ekosistemlerine zarar verebilecek ftalat ve bisfenol A gibi zararlı kimyasal konsantrasyonları içeriyor. İnsan sağlığı da risk altında-insan tüketimi için yakalanan her üç balıktan biri artık plastik içeriyor.
Bakteriler ve karada yetişen mantarlar gibi çeşitli mikroorganizmalar, plastikleri parçalama yetenekleri açısından halihazırda test ediliyor. Herhangi birinin başarılı olması halinde, biyoteknolojinin bu çözümlerin “ekolojik açıdan ugun bir ölçekte” kullanılmasına izin vermesi bekleniyor.
Bilim ilk kez deniz mantarlarını inceliyor
Araştırmacılar, Hawaii’nin yakın kıyısındaki kum, deniz yosunu, mercan ve süngerlerden izole ettikleri büyük bir mantar örneğini inceledikten sonra yeni buluşu gerçekleştirdi. Hazlihazırda, deniz mantarlarının %1’inden daha azının bilim tarafından bilindiği belirtiliyor.
Pasifik Biyobilimler Araştırma Merkezi profesörü Anthony Amend, “Mantarlar, diğer organizmaların sindiremediği şeyleri (ahşap veya kitin gibi) yemek için süper bir güce sahiptir, bu nedenle koleksiyonumuzdaki mantarları plastiği sindirme yetenekleri açısından test ettik” dedi.
Araştırmacılar ayrıca diğer deniz mantarlarını da inceleyerek, onların daha zor bozunan ve daha büyük deniz kirliliği kaynakları olan farklı plastik türlerini yiyip yiyemeyeceklerini de araştırıyor.
Bulacakları çözümlerin gelecekte sahil ve denizlerin kapsamlı bir şekilde temizlenmesinin bir parçası olabileceğini umuyorlar.